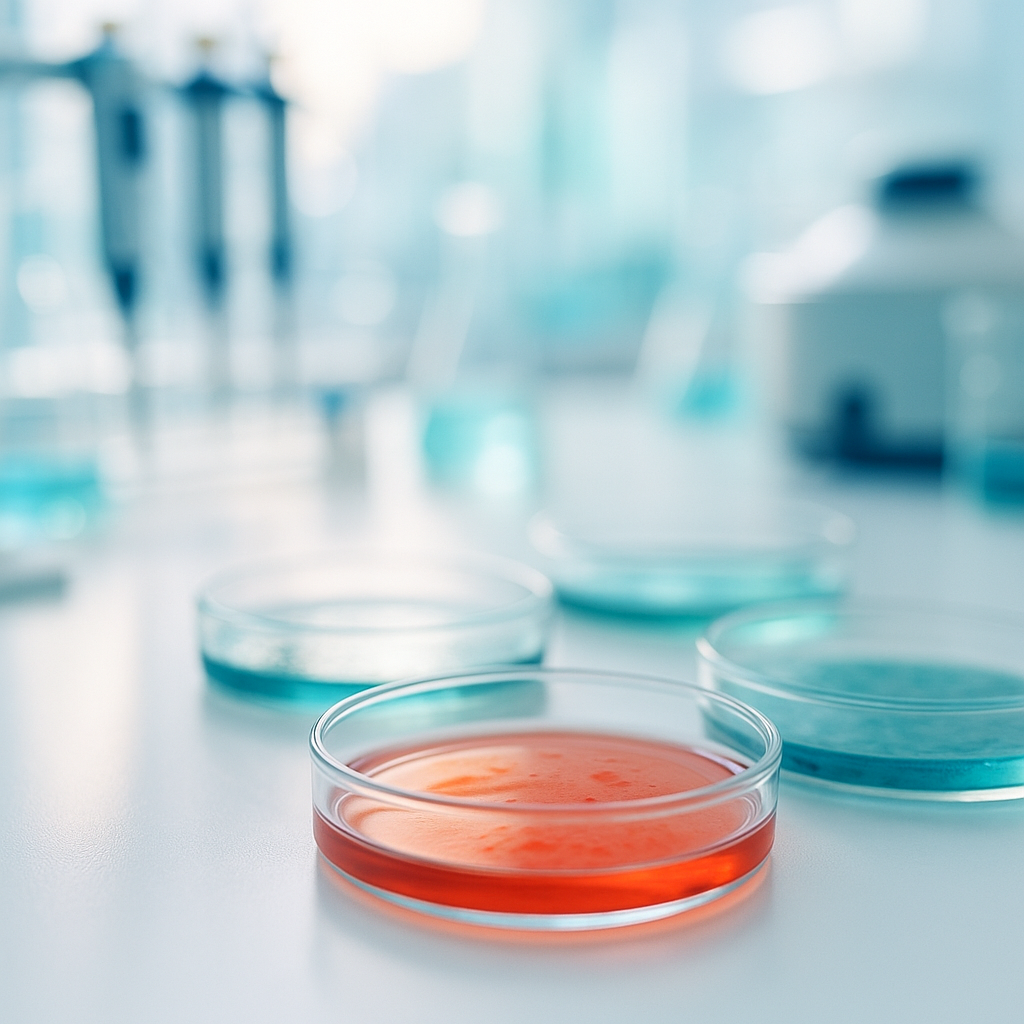
laboratorium

Badania diagnostyczne
POCT (Point of Care Testing)
Szybkie badania diagnostyczne wykonywane bezpośrednio u pacjenta – w domu, bez konieczności wizyty w laboratorium. Dzięki nowoczesnym testom przyłóżkowym możliwe jest uzyskanie wyniku w ciągu kilku – kilkunastu minut, co znacznie przyspiesza diagnozę i rozpoczęcie leczenia.
Zakres badań
- testy antygenowe i serologiczne w kierunku chorób zakaźnych (np. grypa, COVID-19, RSV, paciorkowiec),
- szybkie badania parametrów krwi (CRP, glukoza),
- badanie moczu przy podejrzeniu infekcji układu moczowego.

Zalety badań POCT
👉 Wynik dostępny jest od razu na miejscu, co pozwala lekarzowi szybko postawić diagnozę i wdrożyć odpowiednie leczenie, bez zbędnego czekania.
Ta usługa jest szczególnie cenna dla:
- dzieci, osób starszych i przewlekle chorych,
- pacjentów mających trudności z dojazdem do przychodni,
- osób wymagających szybkiej diagnozy w nagłych sytuacjach.